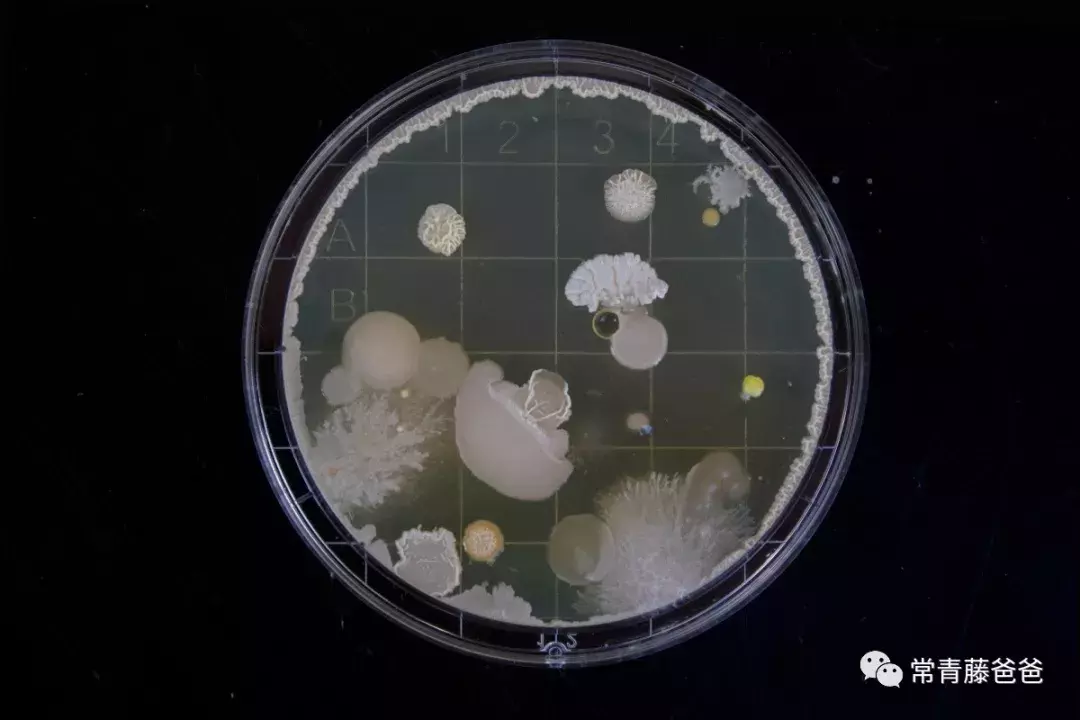
深度剖析孩子吃进肚里的烤肠：肥油、细菌、添加剂、致癌物……

不知道什么时候开始,景点、写字楼、商场、学校附近的路边杂货店、早餐摊位都摆着烤肠机。红亮有光泽的烤肠匀速转着,甚至有些已经烤到外皮爆开,每次路过都异香扑鼻。

有卖相简陋的,自然还有看着更高级讲究一些的。把烤肠铺在黑色“火山石”上面烤,说是更有味道更健康。

这几年,媒体关于路边烤肠的报道和提示其实真不少,只是在度娘上搜了一下“烤肠”而已,排在前面的几乎是一水儿的黑料。
本来我以为在妈妈们这儿,早已将烤肠列入“垃圾食品”黑名单,没想到前几天参加朋友聚会,一个妈妈“骄傲”地说她对孩子从来都是有求必应,坚决“富养”。举的例子就是每次去公园,门口香气扑鼻的烤肠3个起,免得一路看到别人手里举着,孩子眼馋~~
听得常爸倒抽一口凉气,这哪是什么富养,分明就是赤果果地“坑”孩子啊!
有杂货店老板说,“我花200块钱买个烤肠机往这一摆,不用吆喝,香味一出来,大人小孩都忍不住,一天就卖百十来根”。难怪烤肠一年全国能卖出去上百亿根,虽然有多少进入孩子肚里不清楚,但是看前面这情况,少不了。

所以,今天常爸就跟美女营养专家刘遂谦一起,狠心揭开街边劣质烤肠香喷喷的外衣,给你看看又油又脏又毒的内幕!希望看完我们找的资料,孩子在你的带领之下,也会自动“戒毒”。
专家支持: 刘遂谦,和睦家医院临床营养师。

▲刘遂谦
澳大利亚悉尼大学营养学专业硕士,澳大利亚营养师协会认证“临床执业营养师”。有丰富的儿科及孕产妇临床营养经验和婴幼儿及儿童营养指导经验,长期受邀为多家母婴杂志、网站、广播电台及母婴节目供稿、审稿、答疑、访谈、录制等,参与多本营养学专著及教材的中英文翻译及校译。
先说正常的情况。看到烤肠配料表上写的“猪肉、鸡肉、鸭肉”,你脑袋里会想到什么?超市常见的那种猪肉鸡肉对不对。确实,正规肉制品厂会选用肥瘦相间的肉,生产优质香肠。

这样的香肠没啥毛病,好吃,好看,也一定不会便宜。
可是对于街边小商贩,买一台烤肠机不到200块钱,一根烤肠就卖2块钱,你觉得卖家会舍得进实打实的纯好肉做的优质烤肠?

当然谁家便宜买谁家的了,看网上大数据,大部分人买烤肠会选择最便宜那一档。

咱来算笔账,最便宜的猪肉十八九块钱一公斤,鸡肉也要十块钱每公斤。网上一搜,销量较高的一款烤肠居然只卖25.9元/50根/1.9公斤!还有优惠券、包邮、利润等等活动,算下来平均一根烤肠成本不到5毛钱!

这不禁让人要问了,这样价格的“肉”得是什么样子的?
有技术人员在《肉类工业》行业杂志上描述过,考虑到成本,好一些的厂家对烤肠中的肥肉(脂肪)部分,会用猪肥膘、鸡皮、鸭皮,还有些厂家嫌猪肥膘太贵,只用鸡皮鸭皮。
鸡屁股的肥肉尤其好用
这些肥腻腻的皮要加多少呢?国家在各种腊肠烤肠香肠类行业标准中规定,脂肪含量最高不能超过45%。实际上,2003年质检总局查到,有的香肠中脂肪含量超过60%,一根肠至少半根是鸡皮啊,黑心厂家、小作坊只会掺更多!

这还算实在人。有的香肠中蛋白质含量检测值只达到10%,且这10%的蛋白质一部分还来源于添加的大豆蛋白、拉丝蛋白等等,并非都来源于实实在在的肉,个别甚至基本没什么肉,绝大部分成分是淀粉和添加剂。
对于烤肠中的瘦肉部分,好一些的厂家会用鸡胸肉代替猪瘦肉,但是黑心厂家,嘿嘿~~央视新闻曝光过,有的厂家可能还会用狐狸肉、貂肉等。因为养狐狸养貂的养殖场大多只要毛皮,肉没人要,刚好便宜处理给黑心厂家。

有网友在街边买烤肠,就吃出来一撮白毛,这分明是皮没处理干净,细思极恐啊。

这样做出来的烤肠,除了小商贩会进货,还有不明就里的妈妈们也会买回家给孩子吃,大家还都吃得很嗨。

可是知道真相的我!只!想!吐!

HOLD住!咽回去!还没完呢——
这些杂七杂八甚至有些可能变质的肉掺到一起,味儿不对,颜色也不对啊,怎么办?万能添加剂救场!
常爸随手搜了一个烤肠包装袋做例子,看上面一大串的食品添加剂名字:

怕肉变质,加防腐剂(焦磷酸钠、六偏磷酸钠、D-异抗坏血酸钠、亚硝酸钠);怕颜色不够鲜亮,加色素(诱惑红);怕没有肉味儿,吃不起不够香,加香精;怕烤的时候口感不嫩、没有弹性,加增稠剂(乙酰化二淀粉磷酸酯、卡拉胶),保水剂(三聚磷酸钠)……
你以为添加剂是这么撒的……
实际上是这么倒进去的……
《食品添加剂使用卫生标准》(GB2760-2011)对每种添加剂添加量都有详细规定,一般每千克加5μg-3g不等,有些添加剂还有毒性、腐蚀性,不能闻不能接触皮肤,所以正规厂家会严格控制添加剂的添加量。
可是,对小作坊来说,加点添加剂,腐肉的酸臭味没有了;再加点,口感、色泽效果立马就出来了,至于添加量,“国标是啥?我不懂!烤肠好卖我就多加。”坊间甚至流传一个说法,“做烤肠的人基本就不吃那种东西”。
不是说添加剂一点儿不能加,就算加也要受国标约束,接受质监部门的严格监管。但黑作坊们不管这些,人家可不在乎我们每天摄入的添加剂是不是已经足够多!
现在再回头看看鲜嫩多汁、皮脆肉弹、香气四溢、鲜红油亮的烤肠,你还觉得它吸引人吗?在常爸看来,简直就跟《画皮》里披着美女皮的鬼一样恐怖啊!

看到这里又想吐又心凉?
还是别急呢,看完下面的再一起颤抖吧——
俗话说“病从口入”,烤肠工艺本身就决定了它沾染的细菌比较多。
烤肠的生产过程大致是,将生肉绞切、腌渍、添加辅料和香辛料,灌入(可食) 肠衣后,经或不经热处理,速冻保存。所以,烤肠基本是完全生的或者半熟制品。
根据文献,生肉类最常见的细菌有——
(深吸一口气,跟我一起报菜名儿!)
假单胞菌属、希瓦氏菌属、不动杆菌属、莫拉克斯氏菌属、嗜冷杆菌属、产碱杆菌属、肠杆菌科、弧菌科中的气单胞菌属和弧菌属、黄杆菌属、葡萄球菌、微球菌属、梭菌属、乳酸杆菌属、明串珠菌属、环丝菌属、棒状杆菌属等。
(图源:unsplash)
这群细菌,有的嗜冷,有的耐热,有的厌氧,有的耐盐,个个是打不死的小强,烤肠的低温生产过程,基本没有杀菌效果。
正规厂家从源头就开始控制卫生,细菌会少很多。而小公司、小作坊条件有限,又爱用各种狐狸肉和鸡皮。很多和鸡、狐狸的屎尿环境直接接触,绞肉机器也不清洗,工人也随意(美国早年爆出来过工人干着活直接往肉里吐痰的恐怖事件)。一堆堆沾满细菌的肉加上水、糖、淀粉、大豆蛋白粉搅一搅,根本就是一个良好的细菌培养基。

鸡们的生长环境
吃到肚子里,轻的拉肚子、便血、肠胃炎肝炎,重的脑膜炎、肾衰竭、直接死亡。据美国疾病控制和防治中心资料显示,1999年底,在美国密歇根州有14人因食用被李斯特菌污染的“热狗”和熟肉而死亡,另外22个州97人食物中毒,6名妇女流产。2013年还在香肠中查到了肝炎病毒的存在。直到现在,FDA还隔三差五召回被污染的香肠。
美国农业数据库FDA等各种机构都针对烤肠做出过提醒:
孕妇、儿童、老年人和免疫功能弱的人患上食源性疾病的风险可能会增加,产生可怕的后果,所以应特别注意安全处理。
除了生产过程,烤肠进入烤肠机以后也在不停地“造毒”。烤肠中大量的油脂在200~250℃时发生热分解, 会产生稠环芳烃与黑色素,易使人患胃癌。油脂产生自由基, 并相互结合热聚合成苯并芘,苯并芘是目前世界公认的三大强致癌物质之一,可在体内累积。通过长时高温烘烤, 蛋白质会发生变性,产生大量的胺类物质, 其中丙烯酰胺神经毒素亦是一种可能的致癌物质。

(面目狰狞的癌细胞,图:油管)
总的来说,烤肠机里的烤肠,低温消灭不掉本身自带的细菌,高温产生致癌物质,怎么烤,都有毒。
而这些,恐怕一般的小商贩不知道也不去管,只要烤肠没有卖出去,就会一直在烤肠机里转转转,等着孩子上钩。
以上所有,不管哪个环节出了篓子,都会危及孩子健康甚至生命。
知道真相的你,还是决定要继续光顾街边的小贩,或者随意购买来路不明的“烤肠”吗?为了你爱的人的健康,赶紧转发给身边爱吃烤肠的大小朋友们看看吧!
如果觉得“好看”,别忘了点文末右下角的“好看”哦!
参考资料:
王莲学,台湾烤肠出油问题的分析与解决方法[J],肉类工业,2015;
吴亚丽等,市售火腿肠中亚硝酸盐含量的测定[J],广州化工 2015,43(17),151-153;
刘超群,王宏勋,侯温甫.低温肉制品微生物控制与预测模型应用 研究进展[J],食品科学,2009,30(21):481-484;
尹德凤,生鲜肉类产品中腐败细菌研究[J],农产品质量与安全 2018,(03),21-29;
王猛,蒙古族传统饮食制作技艺中存在的食品安全隐患及其改进对策[J],云南农业大学学报 (社会科学) 2017,11(05),106-111;
版权声明:我们致力于保护作者版权,注重分享,被刊用文章【云南农业大学学报(深度剖析孩子吃进肚里的烤肠)】因无法核实真实出处,未能及时与作者取得联系,或有版权异议的,请联系管理员,我们会立即处理! 部分文章是来自自研大数据AI进行生成,内容摘自(百度百科,百度知道,头条百科,中国民法典,刑法,牛津词典,新华词典,汉语词典,国家院校,科普平台)等数据,内容仅供学习参考,不准确地方联系删除处理!;
工作时间:8:00-18:00
客服电话
电子邮件
beimuxi@protonmail.com
扫码二维码
获取最新动态
